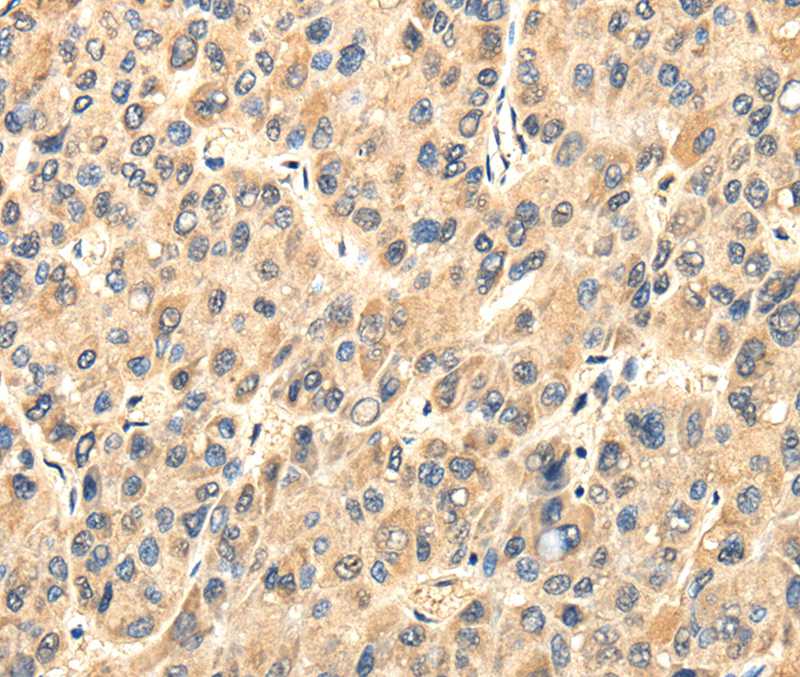
Anti-TWIST2 Antibody

Immunofluorescent staining of human cell line BJ shows localization to nucleus & nucleoli.
Anti-TWIST2 Antibody
HPA062870
ApplicationsImmunoCytoChemistry
Product group Antibodies
ReactivityHuman
TargetTWIST2
Overview
- SupplierAtlas Antibodies
- Product NameAnti-TWIST2 Antibody
- Delivery Days Customer4
- ApplicationsImmunoCytoChemistry
- CertificationResearch Use Only
- ClonalityPolyclonal
- ConjugateUnconjugated
- Gene ID117581
- Target nameTWIST2
- Target descriptiontwist family bHLH transcription factor 2
- Target synonymsAMS, BBRSAY, DERMO1, FFDD3, SETLSS, bHLHa39, twist-related protein 2, class A basic helix-loop-helix protein 39, dermis-expressed protein 1, twist basic helix-loop-helix transcription factor 2, twist homolog 2, twist-related bHLH protein Dermo1
- HostRabbit
- IsotypeIgG
- Protein IDQ8WVJ9
- Protein NameTwist-related protein 2
- Scientific DescriptionRecombinant Protein Epitope Signature Tag (PrEST) antigen sequence
- ReactivityHuman
- Storage Instruction-20°C,2°C to 8°C
- UNSPSC41116161